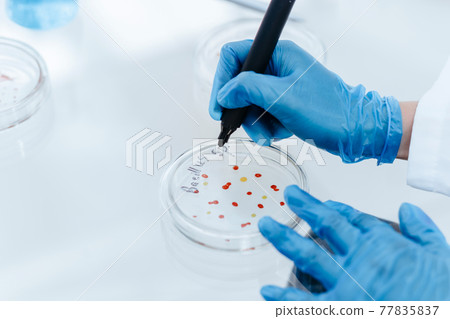

Subscription
Stock Photo: close up. scientist marking a Petri dish with viral bacteria.
Item number : 77835837 See all
This Stock Photo, whose title is "close up. scientist marking a Petri dish with..."[77835837], includes tags of scientist, research, lab. The author of this item is Yuralaitalbert (No.911062). Sizes from S to XL are available and the price starts from US$5.00. You can download watermarked sample data (comp images), check the quality of images, and use Lightbox after signing up for free. See all
close up. scientist marking a Petri dish with viral bacteria.
Scale
* You can move the image by dragging it.
Credits(copyright) : Yuralaitalbert / PIXTA
- About Model and Property Release
- Made at : 2020-06-05
- Views : 85
- Past purchases : No
- Contact Contributor to Ask About This Item